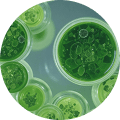

БАД с натуральным пептидом хлореллы Daigo Brainy
Поддержка когнитивных функций и работы мозга, а также нервной системы
Daigo Brainy улучшает работу нервной системы и мозга при информационных и психоэмоциональных перегрузках, способствует профилактике тревожности и депрессии и помогает более быстрому засыпанию, снижает метеочувствительность.
БАД. НЕ ЯВЛЯЕТСЯ ЛЕКАРСТВЕННЫМ СРЕДСТВОМ
Описание товара
Особенности
Натуральный короткий пептид хлореллы в составе Daigo Brainy выделен из микроводоросли Chlorella pyrenoidosa по уникальной технологии IPH в Германии.
Он обладает мощным регулирующим действием, а в сочетании с четырьмя ключевыми аминокислотами — L-изолейцином, L-лейцином, L-глутамином и L-аргинином образует основу для нового поколения препаратов, которые не просто временно решают проблемы, а помогают организму самостоятельно восстанавливать баланс

Уникальные капсулы
60 уникальных пуллулановых капсул в одной упаковке

Высокая усвояемость
Усвояемость в 3 раза выше чем у других пептидов

Восстановление на клеточном уровне
Дайго Брейни убирает скрытое воспаление и очищает от межклеточного мусора

Пептид Хлореллы
Короткая молекулярная структуре, обеспечивает быстрое проникновение в клетки и высокую биодоступность.
Принцип действия

1 этап. Биоразнообразие – повышение функциональности полезных бактерий.
2 этап. Устранение инфламэйджинга (снятие низкомолекулярного воспаления).
3 этап. После эндогенного клининга, то есть запуска реакций по выведению продуктов распада и вредных веществ, происходит самоочищения организма.
4 этап. За счет выполнения предыдущих этапов, происходит направленное усвоение аминокислот и восстановление истощенных зон организма.
Эффект

Daigo Brainy показан при:
- Нарушения памяти, внимания, других когнитивных функций и эмоционально-лабильные расстройства (в т.ч. у больных пожилого возраста)
- Последствиях черепно-мозговой травмы
- Последствия сосудистой мозговой недостаточности (энцефалопатиях различного генеза)
- При астенических расстройствах
- В период повышенных умственных нагрузок и других состояниях с признаками снижения интеллектуальной продуктивности
Состав

Инструкция
по применению

Взрослым
По 1 капсуле 2 раза в день
Во время приема пищи
Курс приема – в течение 3 месяцев 2 раза в год.
Производство революционного продукта Daigo Brainy
В основе Daigo Brainy лежит натуральный короткий пептид хлореллы, полученный путём ферментации белковых остатков зелёных водорослей Chlorella pyrenoidosa по запатентованной немецкой технологии IPH, которая служит примером прозрачности и высокого стандарта качества. Её эффективность подтверждена точной методикой контроля — высокоэффективной жидкостной хроматографией, а соответствие фармакопеям США, Великобритании, Европы и Японии (USP, BP, EP, JP) гарантирует стабильный и безопасный состав. Daigo Brainy создаётся по органической технологии, которая включает: ультразвуковую гомогенизацию, фильтрацию, гидролиз, деликатную экстракцию при температуре 60 градусов и повторную ферментацию, контролируемое охлаждение и крио заморозку, распылительную сушку. Это делает Daigo Brainy чистым комплексом с 98% биодоступностью, где каждый элемент синергично усиливает друг друга, давая максимальный эффект.







Как выбратьправильный товар?
Чтобы подробнее узнать о товарах от Дайго, рекомендуем ознакомиться со статьями на нашем сайте